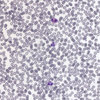

Alice Khan
The Silver Surfer
Venal
Le Cheval de Jérôme Bosch
aka
Vendredi 13
John Connection
Puzzled mini ep
L'Oasis fait son eau
PPP
L'ange exterminateur
Le purgatoire des chiens
Rituals
Pre Ritual Exercises
Cerulean EP
Les Riches Secondes
First Sounds
Second Part
Les Voix Intérieures, première partie (1/2)
Les Voix Intérieures, seconde partie (2/2)
Judgement part 1
Judgement part 2
The One Remains
Long Night